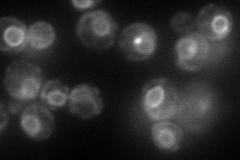

View description
Ceramide synthase component, involved in synthesis of ceramide from C26(acyl)-coenzyme A and dihydrosphingosine or phytosphingosine, functionally equivalent to Lac1p
Localization:
Intensity:
Fold change:
Significance:
-
C’ GFP library in SD

below threshold13.89 -
N' NOP1pr-GFP in SD
cell periphery,ER,punctate125.239 -
N' TEF2pr-mCherry in SD

ER142.152 -
N' NATIVEpr-GFP in SD

punctate,nuclear periphery55.2525 -
N' TEF2pr-VC and Cyto-VN in SD

punctate,nuclear periphery44.1413 -
C’ GFP library in SD+DTT

cytosol14.951.07No -
C’ GFP library in SD+H2O2

cytosol13.941No -
C’ GFP library in Starvation Media

cytosol16.071.15No -
C’ GFP library on the background of Pup2-DaMP

below threshold -
C’ GFP library on the background of CCT mutant

below threshold14.7941.06415No
